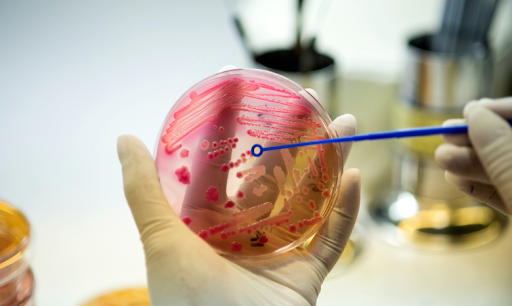

3D Printing, Artificial Intelligence, wearables, telemedicine, gene editing, like these, are new advancements entering medical technology every day. These kinds of technological developments improve many lives and save millions of them. From arranging remote patient monitoring to developing customized implants and artificial organs, science contributed a lot to humanity. If you are a healthcare professional or want to be one, you must be updated with the recent advancements in medical technology to enhance the professional depth. In this article, you can find a list of 11 new medical technolgies with overview to get a better understanding.
1. 3D Printing: Customized implants and prosthetics

3D printing technology has transformed healthcare by enabling the creation of complex anatomical models, custom-made implants, prostheses, and innovative drug delivery systems. Patient-specific implants, such as 3D-printed titanium-mesh structures for bone deformities, have significantly reduced the need for invasive surgeries while improving recovery outcomes. Similarly, 3D-printed anatomical models are now widely used for surgical planning - especially in complicated cases like craniofacial surgery - allowing surgeons to visualize, rehearse, and optimize procedures before entering the operating room. This not only improves accuracy and success rates but also reduces surgery time and patient recovery periods. Beyond implants and models, 3D printing has unlocked new possibilities in prosthetics, pharmaceuticals, and bio-printing. Especially, the rise of bio-printing develops artificial organs such as blood vessels, synthetic ovaries, and even pancreases that can grow within the body and function as natural replacements. These advancements revolutionize individualized patient care, addressing challenges in organ transplantation, reducing rejection risks, and ultimately saving millions of lives.
2. Artificial Intelligence: Smarter diagnostics and decisions

Artificial intelligence (AI) and machine learning are revolutionizing health care by analyzing vast amounts of medical data (images, test results, and patient records) to detect patterns, predict outcomes, and support more accurate diagnoses and personalized treatment plans. Studies have demonstrated its effectiveness across diverse applications like AI models for skin cancer detection, used machine learning to forecast patient mortality and readmissions, and predicted the onset of psychosis in high-risk individuals. While challenges like data privacy and ethical use remain, AI continues to enhance clinical decision-making. Looking ahead, AI holds immense potential to transform health care, offering faster, more precise, and individualized care that could improve outcomes for patients worldwide.
3. Wearables: Real-time health tracking

Wearable health monitoring technology helps the individuals track and manage their health, offering real-time feedback through devices such as fitness trackers and smartwatches. These wearables collect data on physical activity, heart rate, blood oxygen levels, sleep patterns, and other vital health markers, enabling users and health professionals to detect trends and gain insights into overall well-being. By enabling early disease detection, proactive interventions, and continuous health monitoring, wearable technology not only supports healthier lifestyles but also improves patient outcomes and reduces health care costs. Wearables promise an era of personalized, real-time health management, empowering individuals and clinicians alike to make informed decisions and prevent serious health issues before they arise.
4. Telemedicine: Remote healthcare access

In recent years, telemedicine has grown rapidly, especially during the COVID-19 pandemic. This technology helps to deliver medical care remotely. By enabling virtual consultations, remote patient monitoring, and access to medical services in underserved areas, telemedicine has improved health care accessibility and outcomes, particularly for patients with cardiovascular conditions. Studies have shown high patient satisfaction with teleconsultations in dermatology, while evidence indicates that telemedicine can help reduce medical costs. By bridging geographic and logistical barriers, telemedicine offers a convenient and efficient way to connect patients with health care providers. The continued expansion of telemedicine promises to transform health care delivery, making it more accessible, cost-effective, and patient-centered worldwide.
5. CRISPR: Gene editing for treatments

Gene editing, particularly through CRISPR-Cas9, is rapidly transforming medicine by enabling precise modifications to the genome. This technology holds the potential to cure previously untreatable genetic disorders such as cystic fibrosis and sickle cell anemia, while also offering therapeutic possibilities for conditions like Alzheimer’s disease, HIV, and various cancers. However, ethical considerations, especially regarding germline editing, necessitate cautious and responsible use. Despite these challenges, CRISPR represents a groundbreaking advancement in personalized medicine, with the potential to prevent and treat genetic diseases for future generations.
6. Virtual Reality: Ease of Training and rehabilitation

Virtual reality (VR) has emerged as a powerful tool in medical education and training, providing students with safe, controlled environments to practice procedures and clinical scenarios. Studies, including those by Yiasemidou et al., have shown that VR improves surgical skills, confidence, and overall performance. VR also reduces reliance on cadavers or animal models for less common procedures, with applications like transesophageal echocardiography training demonstrating its effectiveness. By enhancing medical training and patient safety, VR has the potential to raise standards in education while preparing clinicians for real-world challenges.
7. Remote Patient Monitoring: Continuous health oversight

Remote patient monitoring (RPM) leverages connected devices and sensors to continuously track patients’ vital signs, symptoms, and chronic conditions outside traditional clinical settings. This technology enables early detection of complications, timely interventions, and better management of chronic diseases such as heart failure, diabetes, and respiratory disorders. RPM improves patient engagement, reduces hospital readmissions, and supports more proactive, personalized care. Looking ahead, widespread adoption of RPM promises a future where continuous, real-time health oversight empowers both patients and clinicians to prevent complications and improve overall health outcomes.
8. mRNA Technology: Faster vaccine development

The development of mRNA vaccines, exemplified by Pfizer-BioNTech and Moderna, has revolutionized infectious disease prevention, demonstrating remarkable efficacy and safety during the COVID-19 pandemic. mRNA technology allows faster vaccine development, lower production costs, and rapid adaptability to emerging viral variants compared with traditional methods. Beyond COVID-19, this platform holds transformative potential for preventing and treating a wide range of diseases, paving the way for faster responses to future pandemics and more personalized immunotherapies.
9. Nanotechnology: Targeted drug delivery

Nanotechnology is reshaping medicine by enabling precise delivery of drugs and therapeutic agents directly to diseased tissues or cells. This approach enhances treatment efficacy, minimizes side effects, and opens possibilities for tackling previously incurable conditions. Recent advances include multifunctional nanoparticles delivering chemotherapy alongside immunomodulators to tumor cells, as well as MRI contrast agents targeting pancreatic cancer. With its ability to improve drug performance and patient outcomes, nanotechnology holds tremendous promise for precision medicine and advanced disease management.
10. Artificial Organs: Engineered organ replacements

Artificial organs, developed from polymers, biological tissues, or hybrid materials, are designed to replicate the form and function of natural organs, offering life-saving solutions for patients with organ failure. Innovations such as the Wearable Artificial Kidney (WAK) and Total Artificial Heart (TAH) enhance quality of life and extend survival for patients awaiting transplants. By mimicking complex organ functions, artificial organs are poised to transform treatment options for end-stage organ diseases, bridging critical gaps in transplantation and regenerative care.
11. Regenerative Therapy: Repairing tissues with stem cells
Regenerative medicine aims to restore, replace, or regenerate damaged tissues and organs using approaches like stem cell therapy, tissue engineering, and gene therapy. Stem cell treatments have shown promising results in conditions such as spinal cord injuries, while 3D-printed tissue and organ models—including liver, pancreas, and heart—offer new avenues for replacement therapies. Gene therapies targeting disorders like sickle cell anemia and cystic fibrosis are yielding encouraging outcomes. By enabling the repair and regeneration of previously untreatable conditions, regenerative medicine represents a transformative frontier in modern health care.
Conclusion
The rapid evolution of medical technologies highlights the need to continuously update skills and knowledge, ensuring that future health professionals are prepared for emerging innovations. Staying at the forefront of these advancements enhances patient care, improves treatment outcomes, and drives the future of health care. At Mahalakshmi College of Allied Health Sciences, we equip students with cutting-edge training and hands-on experience, preparing them to lead in tomorrow’s health care landscape.
FAQ
- Artificial Intelligence and Machine Learning: Improving diagnosis, predicting disease risks, and personalizing treatments.
- Telemedicine and Remote Patient Monitoring: Providing virtual consultations and real-time health tracking.
- Personalized and Precision Medicine: Tailoring therapies based on genetics, lifestyle, and environment for better outcomes.



